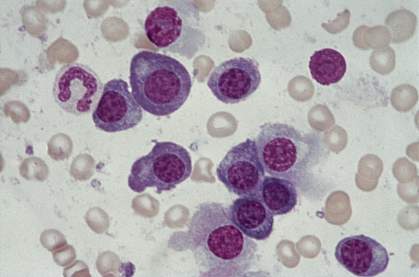

You are here
June 30, 2008
Blocking Protein Kills Myeloma Cells in Laboratory
Researchers have found that blocking the production of a single protein in cells from a blood-borne cancer called multiple myeloma eliminates the cancer cells in laboratory models. The cells rely on the activity of this protein to activate a wide range of genes responsible for cell survival and spread, highlighting it as a potentially powerful therapeutic target.
Multiple myeloma arises from blood plasma cells—antibody-producing cells that develop from the immune system's B cells. There’s no cure, but the disease can sometimes be controlled with chemotherapy, stem cell transplantation or newer treatments.
To identify new treatment targets, scientists at NIH’s National Cancer Institute (NCI) employed a system they recently developed based on a phenomenon called RNA interference. This system uses small snippets of RNA, called short hairpin RNAs, to effectively turn genes off one at a time, allowing researchers to measure the subsequent effects on cell survival and proliferation. The researchers applied this system to 10 multiple myeloma cell lines grown in the laboratory, each representing distinct genetic subtypes of the cancer.
As they reported in the June 22, 2008, online edition of Nature, the scientists found that quenching production of a protein called IRF4 caused all 10 myeloma cell lines to die. However, it had a minimal effect on the 5 lymphoma cell lines used for comparison.
IRF4 is a transcription factor, a protein that helps to activate other genes. The team noted that the list of genes that interact with IRF4 in multiple myeloma cells suggests that these cancerous cells somehow redirect IRF4 to activate a genetic program that it normally doesn’t affect in healthy plasma cells.
One gene in particular stood out from the rest—an oncogene called MYC, known to play a significant role in multiple myeloma and other cancers. Further investigation revealed that IRF4 and MYC form a feedback loop: IRF4 activates MYC, and MYC, in turn, activates IRF4 and—by extension—itself and the myeloma-fueling gene networks that rely on IRF4.
The discovery that multiple myeloma cells are dependent on IRF4 for survival puts a new twist on a hypothesis known as oncogene addiction. The hypothesis suggests that certain cancers rely on the activity of a single mutated gene pathway for proliferation and survival. If this Achilles' heel could be identified and shut down therapeutically, the hypothesis contends, the cancer could be eliminated.
The multiple myeloma case is slightly different because the gene for IRF4, in most cases, isn’t mutated. The cells are “addicted” to the protein's ability to inappropriately activate normally inactive genetic programs. The researchers call it a non-oncogene addiction.
“These findings reveal a hitherto unknown and, for myeloma cells, critical network of gene activity centered on this one protein,” said lead researcher Dr. Louis M. Staudt. “What we have now is a new window of opportunity for therapeutic development in multiple myeloma.”